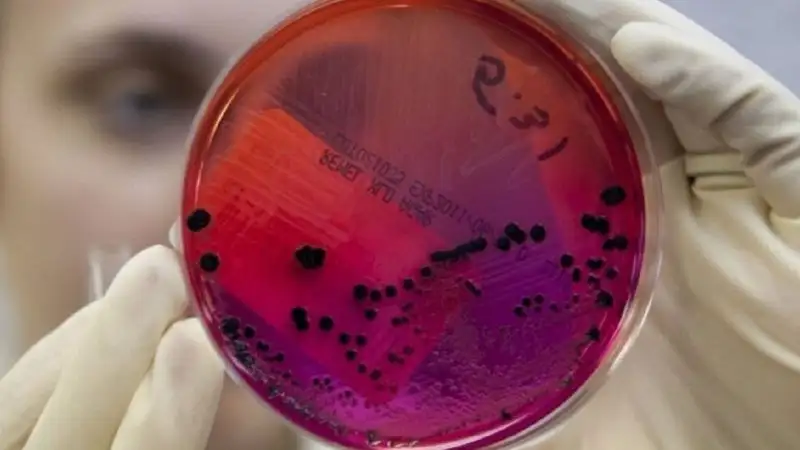

Медики рассказали, как уберечься от сибирской язвы
Фото: wikipedia
Фото: wikipedia
Как выяснилось, это одно из наиболее особо опасных инфекционных заболеваний многих видов животных и человека, характеризующееся поражением кожи, кишечника, легких, лимфатических узлов и высокой смертностью.
Более восприимчивы к заболеванию крупный и мелкий рогатый скот, буйволы, лошади, ослы, олени, верблюды, менее восприимчивы свиньи. Возбудитель сибирской язвы устойчив в окружающей среде. В почве он сохраняется столетиями.
Длительность и признаки заболевания многообразны.
При молниеносной форме у животных наблюдаются судороги, шаткая походка, они падают, изо рта, носа, заднего прохода иногда выделяется кровянистые выделения. Смерть наступает через 30-60 минут.
При острой форме с более длительным течением понижается аппетит, снижается удой у коров, молоко приобретает горький вкус, слизистую консистенцию, кремовый или кровянистый оттенок. У беременных животных могут быть выкидыши. У свиней сибирская язва протекает в виде ангины и сопровождается опуханием шеи. У павших животных кровь дегтярного цвета, не сворачивается. Очень часто она истекает из носа, заднего прохода. Трупного окоченения нет или оно слабо выражено.
Основной путь заражения у животных через корма и воду, а также через укусы насекомых и органы дыхания.
Как человек может заразиться сибирской язвой?
При употреблении продуктов животноводства, не прошедших ветеринарно-санитарную экспертизу, приобретенных в неустановленных местах торговли. Также заражение человека может наступить при уходе за больным животным, убое его, снятии шкур, разделке туш, захоронении трупов, а также при контакте с продуктами животноводства (шкуры, кожи, меховые изделия, шерсть, щетина), обсемененными спорами сибиреязвенного микроба.
Меры профилактики:
- немедленно сообщать обо всех случаях заболевания и падежа животных в ветеринарные учреждения;
- обязательно приглашать ветеринарного специалиста для проведения предубойного осмотра животного;
- категорически запрещается самостоятельное захоронение павших животных;
- категорически запрещается вывоз (ввоз) за пределы населенного пункта больных животных или зараженных продуктов и сырья животного происхождения (при регистрации случаев заболевания);
- категорически запрещается приобретать продукты животного происхождения в местах несанкционированной торговли, без наличия ветеринарных сопроводительных документов;
- при убое домашних животных, после проведения обязательного предубойного осмотра ветеринарным специалистом, необходимо использовать индивидуальные средства защиты (резиновые перчатки, халат);
- при первых признаках заболевания человеку необходимо своевременно обратиться за медицинской помощью.
Ранее мы писали, что сибирской язвой заразились сразу три жителя села Тамды Таласского района Жамбылской области.













